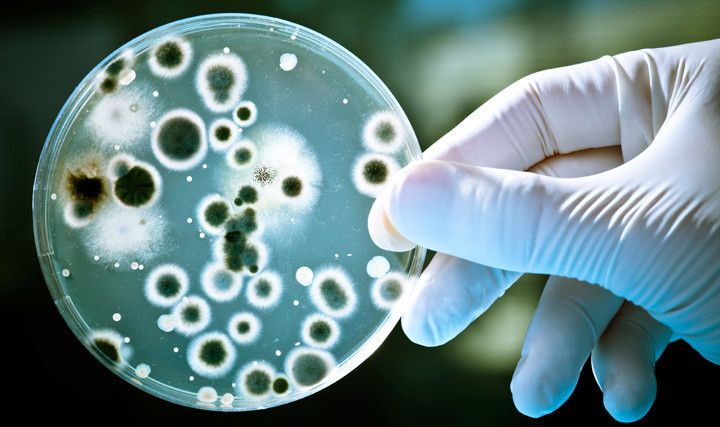

بسبب تناول بعض الاطعمة أو لعوامل أخرى عديدة، تتراكم الجراثيم والبكتيريا في المعدة وتسبب مشاكل عديدة في الجسم، فتضطرون لاستشارة الطبيب بهدف الحصول على دواء يقتل البكتيريا ويقضي على الجراثيم. لكن كما هناك أطعمة مسبّبة للميكروبات، هناك أنواع اخرى تساعد في القضاء عليها. فما هي هذه الاطعمة؟
الاطعمة التي تقتل البكتيريا
- البصل مفيد جداً للجسم، إذ يقتل الميكروبات في الجسم بحيث أنّ المواد البكتيرية التي تتصاعد من سطح البصلة أثناء تقطيعها تقتل الميكروبات التي تسبب تقيّح الجروح. كما أنّ تناول البصل الطازج يقتل الجراثيم المتراكمة في الحلق، الفم والامعاء.
- يحتوي الثوم على مادة الإليسين التي تمنع انتقال العدوى وتقي اللوزتين والحلق من الالتهابات البكتيرية. كما أن الثوم يقي من الديدان في المعدة ويقاوم البكتيريا العنقودية التي تسبب التسمم الغذائي.
- الكرنب له مفعول قوي في قتل البكتيريا وتطهير الجسم من الميكروبات. كذكل، فإنّ عصير الكرنب يحمي الجسم من الالتهابات.
- يحتوي الليمون على الفيتامينات المضادة لأمراض الكوليرا، التيفوئيد والميكروبات التي تسبب مرض السالمونيلا.
- ينقّي اللبن الدم ويطهره من الميكروبات المسؤولة عن خفض مناعة الجسم بالإضافة الى أنه مضاد للسرطان.
- يحارب التوت الالتهابات البولية، إذ يقتل الجراثيم المسبّبة لها كما يساهم بخفض نسبة السرطان في الجسم.
- يعزز الفلفل الاحمر صحة الانسان ويحارب الجراثيم التي تسبب أمراض الانفلونزا.
- تقي السبانخ من أمراض المناعة وتحمي الجسم من العديد من الامراض.
- تقوي الطماطم عضلة القلب وتقتل الفيروسات المسببة للكثير من الامراض.
(صحتي)

